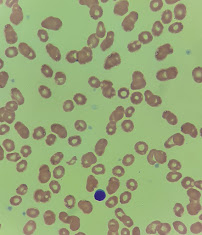

Frottis sanguin: L'artefact d'eau
Un frottis qui a cet allure est un cauchemar à lire. On a beau se déplacer, on ne trouvera probablement pas une belle zone de lecture, on doit se débrouiller avec des globules rouges criblés de petits trous, et parfois ces espèces de bulles biréfringentes s'y superposent. On ne peut pas être certains qu'on ne manque pas d'anomalie qui aurait dû se trouver là où on ne voit maintenant qu'on trou. La coloration est souvent aussi trop pâle. Mais pourquoi ces défauts?
Comme le nom le dit, l'artefact d'eau est provoqué par un excès d'humidité sur le frottis. Il peut survenir de plusieurs manières:
- Le séchage était trop court
- L'humidité de la pièce était trop élevé
- On a soufflé sur le frottis pour le faire sécher plus vite
- La pré-fixation (si requise par la méthode de coloration) a été oubliée ou le méthanol était contaminé par de l'eau
- Le colorant était contaminé par de l'eau
On reconnaîtra plusieurs de ces mécanismes comme ceux qui
causent aussi la cristallisation du colorant.
Le frottis où l'on a découvert l'artefact d'eau est irréversiblement endommagé, on ne peut pas simplement le recolorer. Il faut donc l'étaler à nouveau et, après avoir identifié et corrigé le problème en cause, le colorer à nouveau.
Puisque ce sont les conditions de la coloration qui provoquent cet artefact et non un trait propre au spécimen, les autres frottis manipulés en même temps sons susceptibles d'être aussi affectés, on doit donc les vérifier immédiatement et les refaire avant de dépasser le délai de stabilité des spécimens. Même si le volume de travail ne permet pas de lire tous les frottis immédiatement, en regarder rapidement au moins un par lot peut éviter de se retrouver plus tard avec une dizaine de frottis de mauvaise qualité!
Un artefact de rinçage:
Jetons en passant un coup d'oeil sur un autre artefact provenant de la qualité de la coloration:
Ces deux images montrent des leucocytes dont le noyau semble avoir coulé et taché la cellule autour de lui. Ce n'est pas une anomalie du noyau, un noyau endommagé aurait une apparence tout à fait différente. C'est vers la fin de la coloration, lors de l'étape du rinçage, que le colorant diffuse. Le mécanisme de ce phénomène n'est pas profondément étudié, mais des technologistes ont noté qu'il survenait le plus souvent lorsque la zone de rinçage d'un colorateur automatique est sale et que la nettoyer corrigeait le problème.

Commentaires
Enregistrer un commentaire